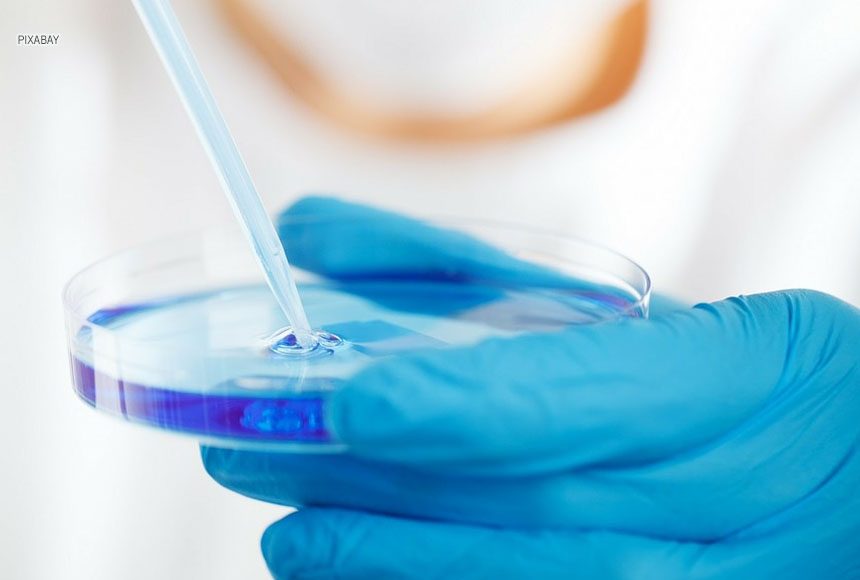

O Instituto de Gestão Estratégica em Saúde do Distrito Federal (Iges-DF) promove, nesta segunda-feira (23), às 14h, o 1º Fórum de Iniciação Científica. Quatro trabalhos de bolsistas da instituição serão apresentados durante o evento, on-line e aberto a todos os interessados.
Os universitários foram selecionados pelo Programa de Iniciação Científica (Pró-Ciência) do Iges-DF em 2019. A iniciativa oferta bolsas mensais de R$ 400 durante um ano, com o objetivo de estimular a investigação científica em áreas da saúde como medicina, fisioterapia e psicologia.
O fomento à pesquisa é um braço de atuação do Iges-DF. Além de administrar o atendimento hospitalar em seis unidades do DF, o instituto estimula a inserção, na pesquisa científica, de estudantes do ensino médio, da graduação e da pós-graduação.
Temas das pesquisas
Dos quatro trabalhos a serem apresentados no evento, dois são de alunos do Centro Universitário de Brasília (UniCeub), um da Universidade de Brasília (UnB) e outro do Centro Universitário do Planalto Central (Uniceplac). Dois foram produzidos na área de fisioterapia e dois na de medicina.
O estudante de medicina Felipe Bruno Santos da Cunha pesquisou sobre o tema epidemiologia das lesões oculares penetrantes no DF. A colega de curso de Felipe, Renata Gabriele de Morais Vargas, avaliou o perfil de sintomas não motores em pacientes com distonia primária e secundária.
Já as alunas de fisioterapia Lara Leocádio Gomes e Carla Carina Duarte investigaram, respectivamente, a adição da eletroestimulação transcraniana por corrente contínua na reabilitação de indivíduos com acidente vascular cerebral agudo e a avaliação da reprodutividade de um sistema automatizado para análise eletrofisiológica neuromuscular por meio do teste de eletrodiagnóstico de estímulo.